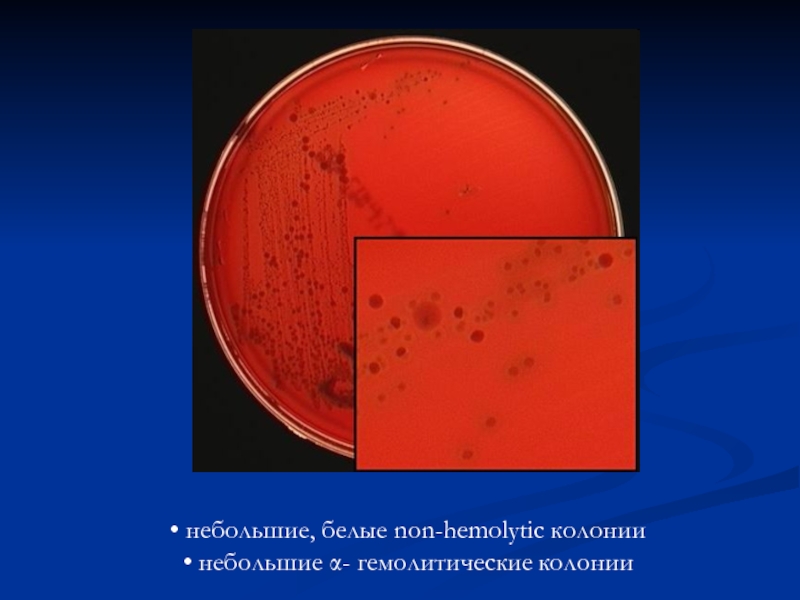
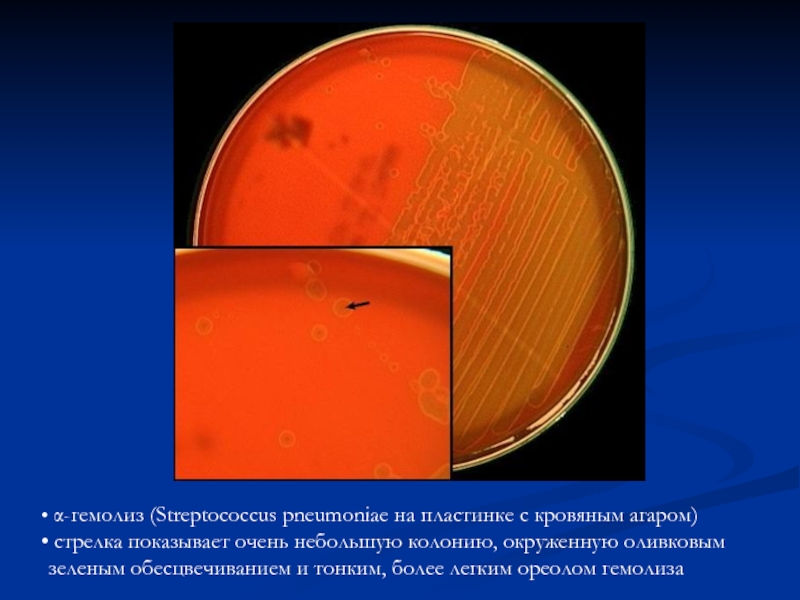

- Главная
- Разное
- Дизайн
- Бизнес и предпринимательство
- Аналитика
- Образование
- Развлечения
- Красота и здоровье
- Финансы
- Государство
- Путешествия
- Спорт
- Недвижимость
- Армия
- Графика
- Культурология
- Еда и кулинария
- Лингвистика
- Английский язык
- Астрономия
- Алгебра
- Биология
- География
- Детские презентации
- Информатика
- История
- Литература
- Маркетинг
- Математика
- Медицина
- Менеджмент
- Музыка
- МХК
- Немецкий язык
- ОБЖ
- Обществознание
- Окружающий мир
- Педагогика
- Русский язык
- Технология
- Физика
- Философия
- Химия
- Шаблоны, картинки для презентаций
- Экология
- Экономика
- Юриспруденция
Инфекции дыхательных путей. Лабораторная диагностика презентация
Содержание
- 1. Инфекции дыхательных путей. Лабораторная диагностика
- 2. Биологическая характеристика отдельных возбудителей.
- 3. Род Streptococcus Морфологические свойства стрептококков: - клетки
- 4. Streptococcus pyogenes (Group A strep) Г +
- 5. Streptococcus pyogenes
- 6. Колонии Streptococcus pyogenes на КА. Видны
- 7. Колонии зеленящих стрептококков на КА. В
- 8. большие β-гемолитические колонии небольшие α- гемолитические колонии
- 9. небольшие, белые non-hemolytic колонии небольшие α- гемолитические колонии
- 10. маленький β-гемолитические колонии небольшие, белые non-hemolytic колонии
- 11. небольшие, белые non-hemolytic колонии небольшие α- гемолитические колонии
- 12. α-гемолиз (Streptococcus pneumoniae на пластинке с
- 13. Биологические свойства стрептококков
- 14. САМР-тест Принцип. Выращивание на кровяном агаре S.
- 15. Тест на чувствительность стрептококков к бацитрацину.
- 16. Факторы патогенности 1. Фимбриальный белок (белок М)
- 17. S.pneumoniae - Основные факторы
- 18. Скарлати́на — инфекционная болезнь, вызванная
- 19. Эпидемиология Стрептококки группы А . Источник
- 20. Род Neisseria Neisseria meningitidis Морфологические свойства :
- 21. N.meningitidis. Чистая культура. Окраска по Граму.
- 22. Культуральные свойства: аэробы, хемоорганотрофы; требовательны к
- 23. Колонии Neisseria meningitidis на КА.
- 24. Биологические свойства нейссерий
- 25. Антигенная структура: 1. Полисахаридная капсула- полимеры аминосахаров
- 26. Факторы патогенности: 1. Основной фактор патогенности капсула
- 27. Эпидемиология: - экологической нишей является слизистая оболочка
- 28. Инфекции, вызываемые менингококками и материал для исследования
- 29. Род Bordetella Морфологические свойства: - мелкие
- 30. B.pertussis. Окраска по Граму.
- 31. Bordetella pertussis на среде Борде—Жангу Bordetella bronchiseptica ( Bordet-Gengou-Agar)
- 32. Биологические свойства бордетелл
- 33. Антигенные свойства: - общие (для всего
- 34. Факторы агрессии: пили (фимбрии), филаментозный геммаглютинин, пертантин
- 35. Эпидемиология: Источник инфекции - больной (особенно в
- 36. СХЕМА БАКТЕРИОЛОГИЧЕСКОГО ИССЛЕДОВАНИЯ 1 день Посев исследуемого
- 37. Род Corynebacterium Морфологические свойства: - тонкие,
- 38. род Corynebacterium окраска щелочной синькой Леффлера. Corynebacterium diphtheriae окраска по методу Грама
- 39. Культуральные свойства: - факультативные аэробы, для бурного
- 40. Corynebacterium diphtheriae colonies on blood agar Corynebacterium diphtheriae en agar Telurito
- 41. Колонии Corynebactrium diphtheriae (внизу) и Corynebactrium pseudodiphtheriticum
- 42. Биохимические свойства коринебактерий
- 43. Антигенная структура: Выделяют О и К Аг;
- 44. Факторы патогенности: - факторы адгезии, колонизации, инвазии
- 45. Биохимические свойства Corynebacterium dihytheriae: Ферментирует с
- 46. Эпидемиология: Источник инфекции – больные или здоровые
- 47. Материал для исследования - при дифтерии носоглотки
- 48. СХЕМА БАКТЕРИОЛОГИЧЕСКОГО ИССЛЕДОВАНИЯ 1 день Посев
- 49. 3 день (48 часов) 1. Учет результатов
- 50. 4 день (72 часа) 1. Учет токсигенных
- 51. Род Legiоnella Морфологические свойства тонкая палочка, способна
- 52. мазок из чистой культуры L.pneumophila
- 53. Legionella pneumophila en BCYE
- 54. Колонии L. pneumophila на BCYE-α агаре, отмечены стрелками
- 55. Биохимические свойства легионелл
- 56. Антигенные свойства: типо и группоспецифические Аг, по
- 57. Схема лабораторной диагностики легионеллеза Клинический/секционный материал
- 58. Род Mycobacterium Классификация микобактерий: по патогенности: собственно
- 59. по способности образовывать пигменты: фотохромогенные (образуют пигмент
- 60. Туберкулез – хроническая инфекция, проявляющаяся поражениями органов
- 61. М. tuberculosis Морфология: грамположительные прямые или
- 62. Микобактерии туберкулеза. Окраска по Романовского-Гимза
- 63. Скопление микобактерий туберкулеза в цепочки
- 64. Люминисцентная микроскопия.
- 65. Культуральные свойства: для культивирования используют специальные
- 66. Культура микобактерий на среде Левенштейна-Йенсена
- 67. Антигены микобактерии содержат протеины, полисахариды, липиды,
- 68. Эпидемиология: источником являются больной бациллярной формой
- 69. Материал для исследования: мокрота, промывные воды
- 70. Лабораторная диагностика: Применяемые методы диагностики:
- 71. В исследуемом материале обнаруживают микобактерии туберкулеза путем
- 72. «обогащение» исследуемого материала Центрифугирование: исследуемый материал обрабатывают
- 73. Бактериологический метод. Достоинство метода — возможность получения
- 74. Бактериологический метод. Материал засевают, тщательно втирая, на
- 75. Для ускоренного обнаружения микобактерий делают
- 76. метод Прайса Материал помещают на предметное стекло,
- 77. биологическая проба - заражают морских свинок с
- 78. Ускоренная биологическая проба: через регионарный лимфатический
- 79. Серологические исследования имеют относительное значение. Кожно-аллергические туберкулиновые
- 80. Забор, хранение и транспортировка мокроты для бактериологического
- 81. Хранение: хранить не более 2 ч при
- 82. Основные правила забора, хранения и транспортировки ликвора
- 83. Хранение: собранный ликвор необходимо срочно доставить в
- 84. Забор материала при бактериальных инфекциях верхних дыхательных
- 85. Забор материала при бактериальных инфекциях нижних дыхательных
- 86. Бактериологическое исследование СМЖ образец СМЖ (мутную
- 87. делают пересев на специальные среды, для подозреваемых
- 88. Бактериологическое исследование мокроты Микроскопический метод.
- 89. Бактериологическое исследование проводят: в первые 4-5 дней
- 90. Выбор среды для первичного посева Ориентируются на
- 91. Дальнейшую идентификацию выделенного возбудителя
- 92. Интерпретация результатов исследования мокроты. обнаружение микроорганизмов в
Слайд 3Род Streptococcus
Морфологические свойства стрептококков:
- клетки стрептококков овоидной формы, могут принимать ланцетовидную
- спор не образуют, некоторые имеют капсулу (S.pneumoniaе).
Культуральные свойства стрептококков:
- лучше растут в присутствии 5 % СО2 микроаэрофилы;
- растут в интервале 25 - 450С, температурный оптимум 370С;
- способны образовывать L – формы.
По характеру роста на кровяном агаре выделяют:
α- гемолитические стрептококки – частичный гемолиз и позеленение среды;
β-гемолитические стрептококки – полный гемолиз;
γ -гемолитические стрептококки - невидимый гемолиз;
- каталазоотрицательные; факультативные анаэробы.
Слайд 4Streptococcus pyogenes (Group A strep) Г + кокки обычно в цепях
Streptococcus pneumoniae
Г + кокки обычно в цепях
Strepococcus pyogenes
Окраска метиленовым синим.
Слайд 6Колонии Streptococcus pyogenes на КА.
Видны характерные гладкие блестящие полупрозрачные колонии
Слайд 7Колонии зеленящих стрептококков на КА.
В культуру внесен диск с пенициллином,
Слайд 12 α-гемолиз (Streptococcus pneumoniae на пластинке с кровяным агаром)
стрелка
Слайд 14САМР-тест Принцип. Выращивание на кровяном агаре S. agalactiae совместно со стафилококком, продуцентом
PYR(L-Pyrrolidonyl-b-Naphthylamide)-тест.
Принцип. Пирролидонил пептидаза (PYR-аза) катализирует гидролиз L-пирролидонил-b-нафтиламида (PYR) с высвобождением не свызанной L-пирролидон карбоксиловой кислоты и b-нафтиламида. Реакция выявляется добавлением специфического цветного индикатора, N,N,-диметил-амино-циннамальдегида, вызывающего красное окрашивание.
Тест с желчью основан на способности 10% желчи и 2% раствора оксихолатов лизировать пневмококк.
Слайд 15Тест на чувствительность стрептококков к бацитрацину.
(Видна зона задержки роста стрептококков
Слайд 16Факторы патогенности
1. Фимбриальный белок (белок М) – антитела к нему обеспечивают
2. Капсула - защищает стрептококк от фагоцитоза, облегчает адгезию к эпителию, проявляет иммунологическую активность.
3. С 5 а-пептидаза - фермент расщепляет и инактивирует С5а компонент комплемента, который является хемоаттрактантом.
4. Гиалуронидаза - облегчает перемещение бактерий по соединительной ткани, осуществляет процессы инвазии.
5. Ферменты -
а) стрептолизины S и O, гиалуронидаза, ДНК-аза, стрептокиназа-инициируют воспалительную реакцию.
б ) энтерогенные токсины, схожи с токсинами стафилококков, бывают 3 типов: А , В, С – проявляют пирогенную активность (действуют на гипоталамус), способствуют появлению высыпаний на коже;
6. Кардиогепатический токсин – вызывает поражение миокарда, способствует образованию гранулем в печени.
Слайд 17S.pneumoniae
- Основные факторы вирулентности :
капсула, которая защищает от
- С-тейхоевая кислота клеточной стенки, активирует комплемент, чем способствует высвобождению медиаторов острой фазы воспаления.
Слайд 18 Скарлати́на — инфекционная болезнь, вызванная обычно бета-гемолитическим стрептококком группы
Слайд 19Эпидемиология
Стрептококки группы А .
Источник инфекции - больной человек или носитель.
Пути
Восприимчивый коллектив : дети и взрослые..
Стрептококки группы В .
- вертикальный путь заражения – заражается плод при прохождении через родовые пути матери;
- воздушно-капельный (Streptococcus pneumoniae).
Слайд 20Род Neisseria
Neisseria meningitidis
Морфологические свойства :
- кокки (диплококки),Гр (-) неподвижные, аспорогенные ,
Для клетки характерен полиморфизм:
мелкие, крупные клетки, палочковидной
формы. Способны переходить в L –формы.
Слайд 22Культуральные свойства:
аэробы, хемоорганотрофы;
требовательны к условиям роста: растут на свежеприготовленных питательных
для роста оптимум pH 7,2 - 7,4, температуры 370С;
рост на питательных средах через 24 часа ;
лучше всего растут на среде Мюллера - Хинтона, которая включает полный набор аминокислот и мясной экстракт;
менингококк очень чувствителен к внешним воздействиям. На твердых и жидких средах культура гибнет через 48 часов, на полужидких сохраняется до месяца (сохранить культуру лучше всего на среде Дорсе, или среде со сливками); при низкой температуре менингококки быстро теряют способность к образованию колоний; при -10 0 С - погибают через 2 часа; при нагревании до 60 0С - погибают через 10 минут; при 800 С - погибают через 2 минуты; при кипячении через 30 секунд погибают.
Слайд 25Антигенная структура:
1. Полисахаридная капсула- полимеры аминосахаров и сиаловых кислот; По капсульному
2. Белки наружной мембраны:
Родовые АГ (белки) – общие для всех нейссерий;
Видовой АГ (белковой природы)
Группоспецифические АГ – гликопротеидный комплекс.
Типоспецифичные АГ (белки)
3. Липополисахариды - оказывают пирогенное действие.
Слайд 26Факторы патогенности:
1. Основной фактор патогенности капсула – она выполняет защитную функцию
2. Эндотоксин.
3. Пили - факторы адгезии к слизистой оболочке носоглотки и тканям мозговой оболочки.
4. Гиалуронидаза, нейраминидаза, гемолизин.
6. Менингококки выделяют Ig A – протеазы.
Слайд 27Эпидемиология:
- экологической нишей является слизистая оболочка носоглотки человека;
- основной источник инфекции
- механизм передачи воздушно - капельный, возможен контактно-бытовой;
- возможно возникновение эпидемии - возбудитель Neisseria meningitidis группы А;
- возбудителе серогруппы В и С вызывают ограниченные вспышки инфекции.
Восприимчивый коллектив – дети и взрослые.
Слайд 29Род Bordetella
Морфологические свойства:
- мелкие коккобациллы; подвижные и неподвижные;
- по Граму
- образуют капсулу (микрокапсулу).
Культуральные свойства:
- для роста нуждаются в никотиновой кислоте, цистеине, метионине;
- строгие аэробы;
- на твердых средах (агар Борде-Жангу, казеиново-угольный агар, молочно -кровяной) образуют колонии небольшие, сероватые, напоминающие капельки ртути или жемчужины, маслянистой консистенции, тонкие с приподнятым центром;
- на кровяных средах, образуют зоны слабого гемолиза;
- на жидких средах дают несильное помутнение, образуют пленку, иногда со спускающимися краями. Через 2 недели образуют осадок, а среда прозрачна.
Слайд 33Антигенные свойства:
- общие (для всего рода), специфические (видовые) Аг;
Видовые АГ
- фактор 12 – для Bordetella bronchiseptica;
- фактор 14 – для Bordetella parapertusis.
Факторы патогенности:
- вирулентные клетки 1 фазы имеют ворсинки, содержащие специфические О -АГ;
- термолабильный коклюшный токсин – пертусис токсин (экзотоксин) - влияет на миграцию лимфоцитов, вызывая лимфоцитоз, стимулирует выработку инсулина;
- специфический цитотоксин вызывает повреждение, приводящее к гибели и десквамации мерцательного эпителия;
- гемагглютинин, проявляющий цитотоксический эффект;
Слайд 34Факторы агрессии: пили (фимбрии), филаментозный геммаглютинин, пертантин – белок наружней мембраны
Токсины: внеклеточная аденилатциклаза - усиливает синтез и накопление цАМФ внутри клеток хозяина, подавляет хемотаксис;
- трахеальный цитотоксин – повреждает эпителиоциты респираторного тракта, стимулирует продукцию цитокинов;
- дерматонекротический токсин – оказывает повреждающее действие на эпителий респираторного тракта;
- термолабильный эндотоксин – липополисахарид клеточной стенки, стимулирует выработку цитокинов, которые повреждают эпителиальные клетки респираторного тракта.
Слайд 35Эпидемиология:
Источник инфекции - больной (особенно в катаральном периоде) и бактерионосители.
Путь передачи
Восприимчивый контингент – взрослые и дети.
Слайд 36СХЕМА БАКТЕРИОЛОГИЧЕСКОГО ИССЛЕДОВАНИЯ
1 день
Посев исследуемого материала на специальные питательные среды: глицерино
Инкубирование в термостате при достаточной влажноси и 360 C (+-10).
3-4 день
После 2-3 суточной инкубации изучают выросше колонии;
Из характерных колоний готовят мазки и окрашивают их по Граму;
На предметном стекле ставят реакцию агглютинации выделенной микробной культуры с иммунной противококлюшной сывороткой, разведенной 1/10 (при титре сыворотки 1/10 000);
Несколько характерных колоний пересевают на питательные среды и инкубируют в термостате при 370 C сутки;
Высевают выделенную культуру на скошенный МПА с добавлением 0,1% тирозина.
5 день
Изучают выросше колонии, готовят мазки, окрашивают их по Граму и микроскопируют.
Просматривают посевы на МПА с тирозином.
Проводят постанвку пробы на уреазу.
Слайд 37 Род Corynebacterium
Морфологические свойства:
- тонкие, изогнутые палочки с закругленными концами, утолщенными
- для возбудителя характерен полиморфизм, проявляющийся в появлении карликовых, кокковидных, толстых форм с колбовидными утолщениями на концах, нитевидные и ветвящиеся формы.
Биовар gravis - образует короткие, неправильной формы палочки с метахроматическими гранулами.
Биовар mitis – образует длинные изогнутые полиморфные палочки, содержащие волютиновые зерна;
Биовар intermedius – образует крупные с бочкообразными очертаниями и внутренними перегородками клетки.
Слайд 38род Corynebacterium
окраска щелочной синькой Леффлера.
Corynebacterium diphtheriae
окраска по методу Грама
Слайд 39Культуральные свойства:
- факультативные аэробы, для бурного роста нужен свободный доступ О2,
- для роста необходимо содержание в среде цистина, гистидина, фенилаланина, метионина, триптофана, лейцина, пролина, глутамина, пимелиновой и никотиновой кислот, β - аланина, микро и макроэлементов.
- плохо растут на простых средах;
- на сывороточных средах (среда Лефлера) колонии появляются через 10-12 часов;
- наиболее распространенная телуритовая среда. В настоящее время используют модификации
- теллурит-шоколадный агар Маклеода: на ней возбудитель образует серовато-черные колонии.
- на жидких средах при росте возбудителя можно увидеть помутнение и осадок.
Слайд 40Corynebacterium diphtheriae
colonies on blood agar
Corynebacterium diphtheriae
en agar Telurito
Слайд 41Колонии Corynebactrium diphtheriae (внизу) и Corynebactrium pseudodiphtheriticum (hofmannii) на кровяно-теллуровом агаре.
Дифтерийная палочка восстанавливает теллур, в результате чего колонии приобретают серовато-чёрный цвет. Палочка Хофманна не восстанавливает теллур и образует колонии бежевого цвета с тёмным центром.
Слайд 43Антигенная структура:
Выделяют О и К Аг;
- термостапбильные О-Аг – дают перекрестные
- липидные и полисахаридные фракции – представлены межвидовыми Аг- термолабильные;
- поверхностные термолабильные К-Аг (нуклеопротеиды, белки) – обеспечивают видовую специфичность;
- корд-фактор, входит в состав микрокапсулы, К-Аг способствует адгезии микробов в месте входных ворот, препятствует фагоцитозу;
- ферменты агрессии и защиты, инвазии: нейраминидаза, гиалуронидазу, гемолизин, дерматонекротоксин.
Слайд 44Факторы патогенности:
- факторы адгезии, колонизации, инвазии ;
- токсический гликопептид, содержащийся в
- экзотоксин, обуславливающий патогенность возбудителя и характер патогенеза.
Слайд 45Биохимические свойства
Corynebacterium dihytheriae:
Ферментирует с образованием кислоты: глюкозу, мальтозу, галактозу, декстрин
Не ферментирует: сахарозу, лактозу, манит.
Не гидролизует мочевину.
Восстанавливает нитраты в нитриты.
Способен продуцировать: каталазу, цистиназу, гиалуронидазу, сукцинатдегидрогеназу, нейраминидазу, ДНКазу.
Не образует индол, уреазу, желатиназу.
Положительна цистеиновая активность .
Образуют бактериоцины.
Слайд 46Эпидемиология:
Источник инфекции – больные или здоровые носители токсигенных дифтерийных микробов.
Механизм передачи
Основной путь передачи – воздушно-капельный;
Факторы передачи – воздух, продукты, предметы обихода, игрушки, белье;
Наибольшую эпидемиологическую опасность представляют больные дифтерией зева, носа и гортани, незначительное значение играют больные дифтерией глаз, кожи и др., способные распространять инфекцию контактным путем (через руки, предметы быта).
Слайд 47Материал для исследования
- при дифтерии носоглотки - дифтиретическая пленка или отделяемое
- при дифтерии половых орагнов – гнойное отделяемое из половых органов;
- при дифтерии глаз – отделяемое конъюнктивы;
- от бактерионосителей – отделяемое слизистой оболочки носа и зева;
- по эпидпоказаниям исследуют пищевые продукты, смывы с различных предметов.
Слайд 48СХЕМА БАКТЕРИОЛОГИЧЕСКОГО ИССЛЕДОВАНИЯ
1 день
Посев исследуемого материала на селективную дифференциально -
2 день (24 часа)
1. Изучение выросших колоний, при возможности - постановка пробы на токсигенность, цистиназу и посев культуры на скошенный сывороточный агар.
2. При использовании транспортной среды необходимо произвести пересев на селективную дифференциально - диагностическую среду.
3. При множественном росте, в случае необходимости, можно провести исследования для выдачи предварительного ответа - дополнительные пробы Пизу, Заксе и посев "подозрительных" колоний в жидкую питательную среду для выявления дифтерийного токсина в РНГА.
Слайд 493 день (48 часов)
1. Учет результатов проб на токсигенность и на
2. Посев чистой культуры, выделенной во второй день исследования, на среды Гисса для изучения биохимических свойств (сахароза, глюкоза, крахмал, мочевина).
3. Повторный просмотр (через 48 часов) чашек первичного посева визуально или с помощью МБС. Постановка проб на токсигенность, цистиназу и отсев колоний на скошенный сывороточный агар.
4. В случае использования транспортной среды, ход исследования см. начиная с п. 1 второго дня и далее по схеме.
5. Выдача бактериологического ответа об отсутствии коринебактерий дифтерии.
6. При постановке РНГА для выявления дифтерийного токсина, при наличии положительного результата в этой реакции и обнаружении у исследуемой культуры фермента цистиназы, отсутствии фермента уреазы, можно выдать предварительный ответ о выделении возбудителя дифтерии.
Слайд 504 день (72 часа)
1. Учет токсигенных свойств культуры, выделенной в 3
2. Учет биохимических свойств культуры (токсигенной или нетоксигенной), выделенной во второй день исследования (через 24 часа инкубации первичного посева).
Выдача бактериологического ответа о выделении нетоксигенных коринебактерий дифтерии с указанием биохимического варианта и дополнительного ответа о биохимических свойствах токсигенных коринебактерий дифтерии, выделенных ранее.
5 день (96 часов)
Выдача бактериологического ответа о выделении (через 48 часов инкубации первичного посева) токсигенных или нетоксигенных коринебактерий дифтерии с указанием биохимического варианта.
Слайд 51Род Legiоnella
Морфологические свойства
тонкая палочка, способна к полиморфизму, Гр (-) , подвижная,спор
Окрашивание по Романовскому Гимзе и Хименесу; жировые
включения окрашивают суданом черным;
Культуральные свойства:
- внутриклеточный паразит, аэроб;
- лучшей средой для культивирования является агар Мюллера-Хинтона с цистеином и ионами железа; угольно- дрожжевой агар;
- на твердой питательной среде на 3 - 5 сутки образуются серые стекловидные колонии, оптимальная температура роста 350С, рН 6,9;
- из жидких сред можно использовать для посева только бульон на основе дрожжевого экстракта с железом и цистеином.
Слайд 56Антигенные свойства:
типо и группоспецифические Аг, по ним выделяют 12
серогрупп.
Факторы патогенности:
-
каталаза – ингибитор токсических метаболитов кислорода
при фагоцитозе;
- термолабильный токсин (цитотоксин, гемолизин); эндотоксины
Эпидемиология:
Основной путь передачи – воздушно-капельный.
Источник - больной человек.
Восприимчивый коллектив взрослые и дети.
Слайд 57Схема лабораторной диагностики легионеллеза
Клинический/секционный материал
Нативный материал
Деконтаминация
(термическая обработка)
Объекты окружающей среды
Деконтаминация
Нативный
МФА
НМФА
ИФА
РАО
ПЦР
Заражение
биопробных
животных
Кислотная
обработка
Термическая
обработка
ПЦР
Посев на питательные среды
Выделение чистой культуры
Идентификация
Слайд 58Род Mycobacterium
Классификация микобактерий:
по патогенности: собственно патогенные (вызывающие конкретные заболевания), потенциально патогенные
по скорости роста: быстрорастущие ( дают видимый рост на 4-7е сутки), медленнорастущие (рост через 7-10 и › дней), и не растущие на искусственных средах.
Слайд 59по способности образовывать пигменты: фотохромогенные (образуют пигмент на свету), скотохромогенные (образуют
Слайд 60Туберкулез – хроническая инфекция, проявляющаяся поражениями органов дыхания, костей, суставов, кожи,
Возбудителями туберкулеза у человека являются М. tuberculosis (более 90% всех случаев туберкулезной инфекции), М. bovis (5%) и М. africanum (около 3%, главным образом среди населения стран тропической Африки).
Слайд 61М. tuberculosis
Морфология:
грамположительные прямые или слегка изогнутые палочки.
Устойчивы к кислотам,
Для окраски применяют метод Циля-Нильсена (ярко-красный цвет).
Возможен переход в фильтрующиеся и L-формы.
Неподвижны, капсул не образуют (образуют микрокапсулу) .
Содержат кислотонеустойчивые гранулы (зерна Муха), располагающиеся в цитоплазме.
Слайд 65Культуральные свойства:
для культивирования используют специальные питательные среды, содержащие яйца, глицерин,
Размножаются микобактерии туберкулеза медленно.
На плотных средах образуются морщинистые, сухие колонии с неровными краями;
В жидких средах на поверхности образуется нежная пленка, которая утолщается и падает на дно, среда при этом остается прозрачной.
Для получения более гомогенного роста микобактерии к питательным средам добавляют твин - 80 (поверхностно-активное вещество).
Слайд 66Культура микобактерий на среде
Левенштейна-Йенсена
.Микобактерии растут в виде типичных морщинистых колоний
Слайд 67Антигены
микобактерии содержат протеины, полисахариды, липиды, фосфатиды. Антитела к ним определяются
Слайд 68Эпидемиология:
источником являются больной бациллярной формой человек, больное животное(крупный рогатый скот,
Механизм передачи: ведущим является аспирационный (воздушно-капельный или воздушно-пылевой путь).
Редко контактно бытовой путь передачи.
Слайд 69Материал для исследования:
мокрота,
промывные воды бронхов,
спинномозговая жидкость,
плевральная жидкость,
гной,
моча,
кал,
пунктат лимфатических узлов.
Слайд 70Лабораторная диагностика:
Применяемые методы диагностики:
бактериоскопический,
бактериологический,
биологический,
серологический,
аллергологический,
ПЦР.
Слайд 71В исследуемом материале обнаруживают микобактерии туберкулеза путем микроскопии мазков, окрашенных по
Бактериоскопию рассматривают как ориентировочный метод.
* Для «обогащения» исследуемого материала используют различные методы, в частности центрифугирование и флотацию.
Слайд 72«обогащение» исследуемого материала
Центрифугирование: исследуемый материал обрабатывают смесью растворов NaCl и NaOH,
Флотация: метод включает обработку материала смесью NaOH, дистиллированной воды и ксилола (или бензола). Образец энергично встряхивают; образующаяся пена всплывает и захватывает микобактерии. Пену отсасывают и готовят мазки.
Слайд 73Бактериологический метод.
Достоинство метода — возможность получения чистой культуры туберкулеза, позволяющая её
Слайд 74Бактериологический метод.
Материал засевают, тщательно втирая, на твёрдые питательные среды
Посевы делают на
Слайд 75
Для ускоренного обнаружения микобактерий делают посевы по методу Прайса, позволяющего получить
Слайд 76метод Прайса
Материал помещают на предметное стекло, обрабатывают серной кислотой, отмывают физиологическим
Стекло вынимают через 3-4 сут. и окрашивают но Цилю-Нильсену.
При микроскопии обнаруживают микроколонии микобактерии возбудителя туберкулеза. Вирулентные бактерии образуют змеевидные, а невирулентные — аморфные микроколонии.
Слайд 77биологическая проба - заражают морских свинок с последующим выделением чистой культуры.
Материал вводится под кожу или в полость живота морским свинкам.
При наличии в материале вирулентных туберкулезных микобактерий обычно на 10-12-й день в месте его введения под кожей образуется уплотнение переходящее в дальнейшем в незаживающую язву.
Свинки погибают от генерализованного туберкулеза через 2-4 месяцам.
Слайд 78Ускоренная биологическая проба:
через регионарный лимфатический узел морской свинки вводят несколько
На 8-10-й день увеличенный лимфатический узел вырезают и исследуют бактериоскопически в препаратах-отпечатках на присутствие туберкулезных микобактерий.
Слайд 79Серологические исследования имеют относительное значение.
Кожно-аллергические туберкулиновые пробы (реакция Манту) ставят с
Слайд 80Забор, хранение и транспортировка мокроты для бактериологического исследования
Забор материала:
перед забором утренней
при заборе материала из глубины бронхов используют защищенные щеточки, что предохраняет материал от контаминации флорой верхних дыхательных путей;
при исследовании трахеобронхиального содержимого при заборе материала используют стерильный шприц, который вводят в трахею. Для этого необходимо ввести 10 мл стерильного физиологического раствора, вызывая рефлекс кашля, откашливаемый смыв помещают в стерильную посуду.
Слайд 81Хранение:
хранить не более 2 ч при комнатной температуре.
Пробу хранят в
Транспортировка:
используют стерильную одноразовую емкость с завинчивающейся крышкой (для сбора мокроты).
Слайд 82Основные правила забора, хранения и транспортировки ликвора для бактериологического исследования
Забор материала:
взятие
ликвор собирают в стерильную пробирку с герметично закрывающейся крышкой. Обычно материал собирают в три пробирки для микробиологического, клинического и биохимического анализа;
при подозрении на туберкулезную или грибковую инфекцию у взрослых берут не менее 10 мл исследуемого материала;
доставленный, в лабораторию образец СМЖ, первоначально центрифугируют, используя осадок для приготовления мазка и посева.
Слайд 83Хранение:
собранный ликвор необходимо срочно доставить в лабораторию. Сохранить его можно при
Транспортировка:
в стерильных одноразовых пробирках с завинчивающейся пробкой;
в шприце с иглой , воткнутой в стерильную резиновую пробку;
в пробирке с тиогликолевой средой, закрытой стерильной резиновой пробкой;
в транспортировочной емкости для сохранения анаэробов.
Слайд 84Забор материала при бактериальных инфекциях верхних дыхательных путей
отделяемое носовых ходов берут
материал из области хоан забирают стерильным заднеглоточным тампоном;
при бактериальных синуситах исследуют аспират из придаточных пазух;
при фарингитах материал забирают тампоном с задней стенки глотки при широко открытой полости рта (язык фиксируют шпателем). Тампон не должен касаться языка и слизистой оболочки полости рта;
при тонзиллитах материал забирают с миндалин, так как возбудитель находится в складках и ткани миндалин. Полость рта и глотку тщательно прополаскивают стерильным физиологическим раствором;
при склероме (атрофической и рубцовой формах) - содержимое дыхательных путей забирают тампоном раздельно из обеих половин носовой полости .
Слайд 85Забор материала при бактериальных инфекциях нижних дыхательных путей
пробы смыва с бронхов
бронхоальвеолярный лаваж - смыв с бронхов, соскоб с бронхов, образцы транстрахеальной биопсии получают при введении бронхоскопа трансназально или трансорально или через эндотрахеальную трубку;
Пробы соскоба с бронхов:
- через биопсийный канал бронхоскопа вводят телескопический двойной катетер. Собирают материал в стерильный одноразовый контейнер с завинчивающейся крышкой или транспортировочную емкость для анаэробов;
- при заборе трансбронхиального биоптата собирают пробу через биопсийный канал бронхоскопа, помещают ее в стерильный одноразовый контейнер с физиологическим раствором или в пробирку с тиогликолевой средой.
Аспират легких:
- при аспирации иглу через грудину вводят в инфильтрат легкого под контролем сканера томографа. Аспирацию проводят из очага воспаления. Материал помещают в транспортировочный контейнер со средой для анаэробов или в стеклянную пробирку с тиогликолевой средой.
Биоптат легких:
- получают при операционном вмешательстве. Забирают кусочки ткани величиной до 3 см 2 ( если очаг воспаления большой, берут несколько проб). Материал помещают в стрильный одноразовый контейнер или транспортировочную емкость со средой для анаэробов.
Слайд 86Бактериологическое исследование СМЖ
образец СМЖ (мутную или опалесцирующую) первоначально центрифугируют, используя
мазок окрашивают метиленовым синим. При обнаружении в мазке бактерий возможна выдача предварительного ответа;
независимо от результатов микроскопии осадок засевают на чашки- с шоколадным агаром, 20% сывороточным агаром и МПА;
засеянные чашки инкубируют в эксикаторе в атмосфере 5 % - 7 % СО2 (со свечой) строго при 370С. Через 24 часа посевы просматривают, учитывают культуральные свойства. Из выросших колоний делают мазки, окрашивают по Граму и микроскопируют;
Слайд 87делают пересев на специальные среды, для подозреваемых видов, с целью накопления
если на агаровых средах через 24 часа инкубации рост колоний отсутствует, посевы оставляют еще на 24 часа;
из флакона с посевом СМЖ на среде обогащения делают высевы по 0,3-0,5 мл, на упомянутые выше среды;
Результаты регистрируют через 24-48 часов. Окончательную идентификацию возбудителя проводят по биохимическим и антигенным свойствам. В надосадочной жидкости центрифугата с помощью РПГА, ИФА можно обнаружить АГ менингококка или других возбудителей.
Слайд 88Бактериологическое исследование мокроты
Микроскопический метод.
используют в качестве ориентировочной экспресс-диагностики.
мазки готовят
Результат микроскопии мазков из мокроты дает существенную информацию о природе возбудителя.
обнаружение Гр (+) кокков, окруженных неокрашенным фоном, позволяет предположить наличие S.pneumoniaе;
мелких Гр (-) бактерий - H. influenzae;
Гр (-) диплобактерий, расположенных интрацеллюлярно или экстрацеллюлярно – Moraxella сatarrhalis;
Гр (+) , гроздевидно расположенных кокков - S. аurеus;
Гр (-) палочек, с закругленными концами - энтеробактерий или псевдомонад.
цепочек Гр (+) кокков - стрептококков .
Слайд 89Бактериологическое исследование проводят:
в первые 4-5 дней от начала заболевания;
желательно до начала
повторное исследование проводят в случае, неэффективности антибактериальной терапии, при затяжном течении пневмонии, при сохранении рентгенологических, клинических и лабораторных данных.
Слайд 90Выбор среды для первичного посева
Ориентируются на результаты микроскопии.
Для выделения:
- S.pneumoniaе,
- стафилококков используют ЖСА;
- энтеробактерий используют среду Эндо;
- дрожжеподобных грибов среду Сабуро.
Слайд 91 Дальнейшую идентификацию выделенного возбудителя проводят по общепринятой схеме.
Слайд 92Интерпретация результатов исследования мокроты.
обнаружение микроорганизмов в разведении 105 КОЕ/мл расценивают как
в случае исследования эндотрахеального аспирата диагностическим считают выделение микроорганизмов из разведения 106 КОЕ/мл.
инвазивный метод забора материала возможен с помощью защищенной щетки;
рост при разведении 103 КОЕ/мл служит доказательством инфекционного процесса;
альтернативным способом считается защищенный бронхоальвеолярный лаваж, при котором обнаружение более 104 КОЕ/мл считается доказательством инфицирующей роли микроорганизмов.
Для диагностики атипичных пневмоний используются методы иммуноиндикации (РИФ, РПГА) и серодиагностики (ИФА, РПГА).